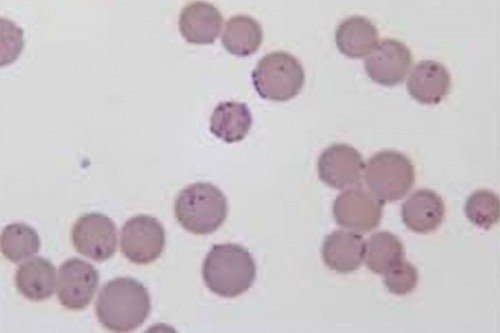

Mongolia reports outbreak of contagious caprine pleuropneumonia
Ulan Bator, Oct 22 (IANS) An outbreak of contagious caprine pleuropneumonia (CCPP), a severe disease affecting goats caused by the bacterium Mycoplasma capricolum subsp. capripneumoniae, has been reported in the southeastern Dornogovi province of Mongolia, according to the country's General Authority for Veterinary Services on Tuesday.
CCPP has not been reported in Mongolia since the 1950s, marking a 70-year absence, the authority noted in a statement.
It is estimated that approximately 15,000 goats belonging to more than 70 herding families in the Khatanbulag soum (administrative subdivision) of the province have been infected. The authority said that measures are being implemented to limit the spread of the disease and to cull the infected goats, Xinhua news agency reported.
The highly contagious disease spreads between animals in close contact through infected respiratory droplets. In goats, symptoms include anorexia, fever, and respiratory issues such as dyspnea, polypnea, coughing, and nasal discharge.
Mongolia is one of the world's last surviving nomadic countries, and livestock husbandry is seen as a viable solution to diversify the landlocked nation's mining-dependent economy. As of the end of 2023, the country had 64.7 million livestock, with goats accounting for 38.1 per cent of the total, according to the National Statistics Office.

|

|

